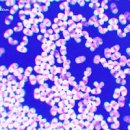
송화가루 효능 송화가루 이미지

카페검색 본문
카페글 본문
-
송화가루의 효능과 복용법 2025.08.08해당카페글 미리보기
송화가루 효능 BEST 7 1. 면역력 강화 비타민 B, C, E와 셀레늄이 풍부하여 면역세포를 활성화합니다. 환절기 감기 예방과 감염 저항력 향상에 도움을 줍니다. 2. 갱년기 증상 완화 천연 식물성 호르몬(식물 스테롤)이 함유되어 있어 여성 호르몬 균형에...
-
송화가루의 효능과 작용 2024.10.31해당카페글 미리보기
송화가루의 효능과 작용 효능 및 특성송화차(松花茶)는 중풍·고혈압 및 심장병에 가장 좋은 차이다. 또 폐를 보하고신경통, 두통등에도 효과가 있다. 송화(松花)는 솔잎, 송지(松脂)와 송엽(松葉)보다약효가 더 좋다.고 혈압 및 치매효과송화가루에 함유...
-
송화가루 효능 3가지 2025.07.14해당카페글 미리보기
송화가루 효능 3가지 한편 송화가루는 채집을 하여 식용으로 사용하기도 하는데요. 솔잎의 성분 및 효능과 비슷하나 약효가 더 좋다고 합니다. 보통 차, 술에 섞어 마시거나 다식을 만들어 먹습니다. 송화가루의 효능 알아볼까요~ 송화가루는 다량의...
-
소나무 개화시기 송화가루 용도 효능 먹는 법 2025.06.05해당카페글 미리보기
송화가루의 놀라운 효능 송화가루는 예로부터 귀한 약재이자 건강식품으로 여겨져 왔습니다. '동의보감'에도 송화가루가 오장육부를 편안하게 하고 기력을 돋우며, 풍을 다스린다고 기록되어 있을 정도로 그 효능을 인정받았습니다. 송화가루가 지닌 주요...
-
소나무 꽃 송화가루 용도 솔방울 효능 복령 효능 소나무 번식 2025.06.05해당카페글 미리보기
가구재, 약재 등 다양한 용도로 활용될 뿐만 아니라, 아름다운 경관을 만들어내는 중요한 요소이기도 합니다. 소나무 꽃과 송화가루 namu.wiki 소나무는 봄에 꽃을 피웁니다. 소나무 꽃은 암꽃과 수꽃으로 나뉘는데, 수꽃은 가지 끝에 여러 개가 모여 달려...
-
소나무꽃 송화 채취시기 채취하는방법 솔잎의효능 2025.06.06해당카페글 미리보기
꼭 짜낸 후, 그늘에 바싹 말려 보관합니다. 이 과정에서 뭉친 가루는 손으로 비벼 풀어주면서 말리면 됩니다. 송화가루의 놀라운 효능과 활용법 송화가루는 예로부터 귀한 약재이자 식재료로 사용되어 왔습니다. 솔잎의 성분과 효능과 비슷하지만 약효는...
-
송화가루 효능 송화가루 2025.01.25해당카페글 미리보기
담다 봄철 소나무에서 흩날리는 노란 꽃가루, 송화가루는 단순한 꽃가루가 아닙니다. 오랜 세월 한방에서 귀하게 여겨온 송화가루는 다양한 을 지니고 있어 현대인들의 건강을 위한 자연의 선물로 주목받고 있습니다. 송화가루란 무엇일까요? 송화가루...
-
송화가루 효능 날리는 시기 날릴때 알레르기 (송화분 송악 송학) 2025.03.22해당카페글 미리보기
가려움증이나 붉은 반점이 나타날 수 있습니다. 송화가루의 효능 ystazo..com 송화가루를 이용한 차 송화가루는 알레르기를 유발하기도 하지만, 동시에 다양한 효능을 가지고 있습니다. 항산화 작용: 송화가루에는 강력한 항산화 성분이 함유되어 있어...
-
해당카페글 미리보기
-
송화가루 효능 정보와 송화가루 알레르기 증상 주의사항! 2024.08.22해당카페글 미리보기
있지 않습니다. 송화가루는 전통적으로 여러 가지 건강 문제를 치료하거나 예방하는 데 사용되어 왔습니다. 이 글을 통해 송화가루의 효능, 알레르기 증상, 그리고 이에 대한 주의사항을 알아봅시다. ## 송화가루의 효능 송화가루는 고단백, 저지방 식품...